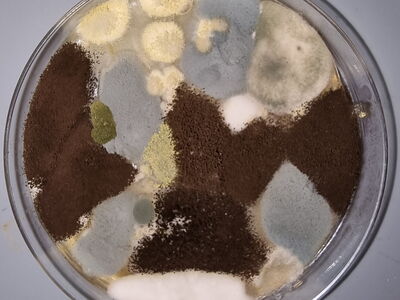

Schmerzen
Lieber Herr Dr. Loosli, vielen Dank für Ihre Behandlung.
Ich konnte gestern Abend endlich 7 Stunden schlafen ohne Unterbrechung (von 22:00 bis 5:00)! Ich kann mich nicht mehr erinnern, ob ich in den letzten 28 Monaten je einmal so viele Stunden am Stück schlafen konnte. Ich habe gestern Abend zum zweiten Mal Magnesium genommen. Ich muss ständig, die Schmerzdosis Medikamenten reduzieren, weil es mir besser geht. Ich werde ihnen mein updated Schmerzprotokoll am Mittwoch zeigen.
Herzliche Grüsse